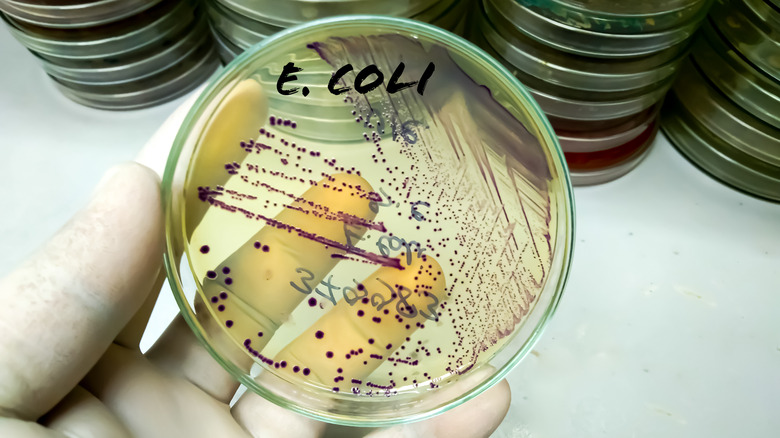
E. coli in a petri dish

The McDonald's Food Vendor Recall That Impacted 18,000 Cases Of Product
For both customers and retailers alike, there is little worse than news of a recall. Whether products are tainted with foreign objects, contain unlabeled allergens, or are infected with hazardous pathogens, the very knowledge that the food on your plate might cause you harm is more than enough to spark anxiety in even the most easy-going diner. Though many outbreaks of contamination are caught and contained quickly, there are some food-borne illnesses so devastating that their discovery can damage the reputation of a business (and even whole industries) for years. Take, for example, the E. coli outbreak that happened at Jack in the Box in the early 1990s, which was one of the worst E. coli outbreaks in American history. Though the business still exists, the damage done to its reputation caused many restaurant closures. More recently, in 2024, the fast food mammoth McDonald's faced its own E. coli outbreak, which was traced to onions used on its Quarter Pounder burgers.
A total of 104 cases of E. coli infections were reported during the span of this outbreak across 14 states, with most cases in Colorado and the surrounding states. Ultimately, the outbreak was tied to a Taylor Farms facility located in Colorado Springs, Colorado. The first reported case of E. coli came on September 12, 2024, and the outbreak officially ended in December of that same year, following over 100 illnesses and one death. Ultimately, McDonald's had to remove just under 18,000 cases of onions from its stores.
What makes E. coli so dangerous?
Though there are many potentially dangerous food-borne pathogens that can cause illnesses, E. coli is one of the most feared of the bunch. While there are many strains of the bacteria that cause relatively minor illnesses in those who consume contaminated items, there are certain strains that can cause extreme illnesses and even death, especially in the elderly, those with weakened immune systems, and children. More severe infections are often linked to strains of the bacteria that produce Shiga, a toxin that can cause cell death by stopping cells from properly forming. More complicated infections can cause bleeding in your digestive tract as well as kidney damage.
The strain that caused the 2024 McDonald's outbreak was E. coli O157: H7. This type of E. coli is a STEC (Shiga toxin-producing E. coli), and therefore more likely to cause severe illness. Ultimately, 34 out of the 104 reported cases resulted in hospitalization. Symptoms of infection range in severity but can include nausea, diarrhea, cramping, vomiting, fever, body aches, headache, and more. More acute infections can cause seizures, kidney failure, and hemolytic uremic syndrome. This syndrome can also contribute to kidney failure, which is often associated with more severe cases.
The E. coli outbreak that changed everything
The 2024 McDonald's E. coli outbreak spanned over two months and caused illnesses in consumers across over 10 states. Still, it pales in comparison to the worst food-borne pathogen outbreaks on record, and we aren't talking about the ergot poisoning theory of the Salem Witch Trials. Over the past few decades, there have been a few severe outbreaks, and one of the most notorious of them was the aforementioned outbreak from Jack in the Box that happened between 1992 and 1993.
This outbreak was linked to the chain's ground beef and also involved E. coli O157: H7. The incident led to four deaths and nearly 200 hospitalizations and helped to create more rigorous standards of food safety. One of the biggest changes was a new rule making E. coli 0157: H7 an official contaminant that must be reported to the CDC. This rule also prevents meat infected with the bacteria from being sold.
Since this event, there has been a sharp decrease in E. coli outbreaks linked to meat products. Still, the bacteria remains a risk, so it is important to take proper precautions when preparing food. Make sure to cook your meat to the proper internal temperature, and prevent cross-contamination to reduce the risk of food poisoning. It's also important to note that fruits and vegetables are also at risk of E. coli contamination, so be sure to keep abreast of any and all recalls.